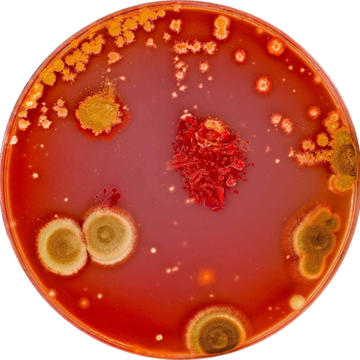

The GRAS (Generally Recognized as Safe) designation is a U.S. FDA classification that allows food ingredients—including probiotics—to be legally marketed when qualified experts determine they are safe for their intended use. Probiotics are live microorganisms that can support gut health, immunity, and other beneficial functions. When added to foods or beverages in the U.S., GRAS status is often required to confirm their safety and enable lawful market access. Under the current U.S. regulatory framework, probiotics are not a separate FDA category—they’re regulated according to intended use and claims. Novel probiotic strains without a history of dietary use may be regulated as food additives, requiring either a Food Additive Petition (FAP) or GRAS status before entering the market.
There are two primary GRAS pathways for probiotics:
- Self-Affirmed GRAS – A safety assessment reviewed by a panel of qualified experts. No FDA notification is required; documentation is kept on file for compliance.
- FDA-Notified GRAS – A GRAS dossier submitted to the FDA for review. A “no questions” letter and public listing in the FDA GRAS Inventory provide added transparency and marketing credibility.